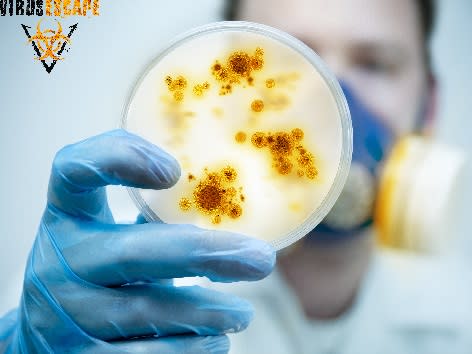
Virus Escape: Scientists

Mark as done to rate
Ypres, city of peace. Until now. Criminals are targeting the city, and want to spread a dangerous virus. Together with your fellow scientists you are the city's last resort. Will you succeed in developing an antidote within the hour?
- 2-7
- 60 mins
- Hard